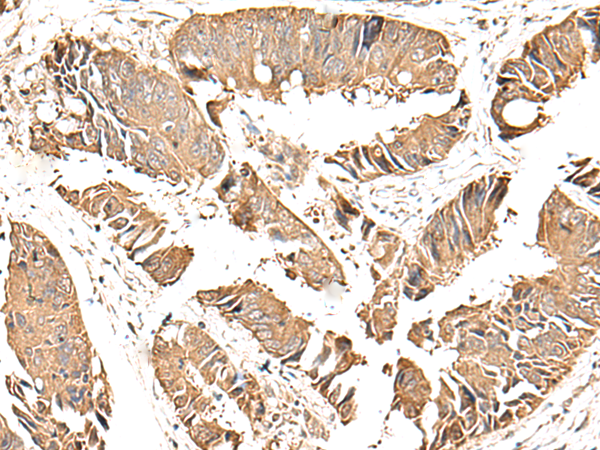

|
Background: |
This gene encodes a protein that functions in bone formation and skeletal development. Mutations in this gene, as well as in a neighboring gene that lies in a head-to-head configuration, cause Ellis-van Creveld syndrome, an autosomal recessive skeletal dysplasia that is also known as chondroectodermal dysplasia. Mutations in this gene also cause acrofacial dysostosis Weyers type, also referred to as Curry-Hall syndrome, a disease that combines limb and facial abnormalities. Alternative splicing results in multiple transcript variants. |
|
Applications: |
ELISA, WB, IHC |
|
Name of antibody: |
EVC2 |
|
Immunogen: |
Synthetic peptide of human EVC2 |
|
Full name: |
EvC ciliary complex subunit 2 |
|
Synonyms: |
LBN; WAD |
|
SwissProt: |
Q86UK5 |
|
ELISA Recommended dilution: |
2000-5000 |
|
IHC positive control: |
Human cervical cancer and Human colorectal cancer |
|
IHC Recommend dilution: |
50-300 |
|
WB Predicted band size: |
148 kDa |
|
WB Positive control: |
Raji and A375 cell lysates |
|
WB Recommended dilution: |
500-2000 |

購(gòu)物車
幫助
021-54845833/15800441009
